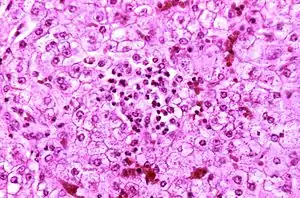

نشانگان ری
سندروم ری یا نشانگان ری (انگلیسی: Reye's syndrome) نوعی انسفالوپاتی پیشرونده سریع است.[1] نشانههای ان عموماً استفراغ، کاهش هوشیاری، تشنج یا حملههای عصبی، تغییرات شخصیتی و گیجی را شامل میشود. علیرغم اینکه در این سندروم مسمومیت کبدی رخ میدهد، معمولاً زردی مشاهده نمیشود.[2] دید دوتایی، کاهش قدرت شنوایی، از دست دادن عملکرد عضلات، یا فلج بازوها یا پاها، مشکلات در گفتار و ضعف در بازوها یا پاها از دیگر نشانههای این سندروم هستند. ۲۰ تا ۴۰ درصد موارد به مرگ منجر میشود و یک سوم رهایی یافتگان با آسیبهای مغزی قابل توجهی روبرو خواهند بود.[3] از آنجا که این بیماری در ۹۰ درصد موارد همراه مصرف آسپرین دیده شدهاست، لذا در حال حاضر مصرف آسپرین جز در مورد بیماری سندرم کاوازاکی در کودکان ممنوع شدهاست[3] و با این اقدام پیشگیرانه شیوع این سندروم به میزان زیادی (تا حد ۹۰ درصد) کم شدهاست.[2]
| نشانگان ری | |
|---|---|
![]() | |
| تصویری از کبد یک کودک که بر اثر نشانگان ری درگذشته است زیر میکروسکوپ. هپاتوسیت به رنگ بنفش مشاهده میشوند. | |
| طرز تلفظ |
|
| طبقهبندی و منابع بیرونی | |
| تخصص | pediatrics |
| آیسیدی-۱۰ | G93.7 |
| دادگان بیماریها | 11463 |
| مدلاین پلاس | 001565 |
| ئیمدیسین | emerg/۳۹۹ |
| پیشنت پلاس | نشانگان ری |
| سمپ | D012202 |
| اورفانت | ۳۰۹۶ |
علت
اگرچه علت این سندروم هنوز مشخص نیست، اما به دلیل استفاده از آسپیرین برای درمان آبله مرغان یا آنفلوآنزا در کودکان پدیدار میشود.[4] نقص ذاتی در متابولیسم عامل خطر برای این سندروم شناخته میگردد.[5]
علایم ونشانهها
این بیماری دارای ۵ مرحله است:[6][7][8]
مرحله I:
- بثورات یا راش (Rash) در کف دست و پا
- استفراغ ممتد که علیرغم غذا نخوردن همچنان ادامه مییابد
- خواب آلودگی یا لتارژی (Lethargy)
- گیجی یا کنفوزیون (Confusion)
- کابوس
- فقدان تب معمول است[9]
- سردرد
مرحله II:
- خواب آلودگی شدید در مرحله قبل کما که استوپور نامیده میشود(Stupor)
- تنفسهای سریع و عمیق که هیپرونتیلاسیون نام دارد (Hyperventilation)
- بروز کبد چرب که توسط بیوپسی تشخیص میخورد
- شدید شدن رفلسهای تاندونی(Hyperactive reflexes)
مرحله III:
- تداوم علایم دو مرحله قبلی
- در این مرحله بروز کمای سطحی محتمل است
- در این مرحله بروز ادم مغزی محتمل است
- به ندرت احتمال ایست تنفسی وجود دارد
مرحله IV:
- کما از مرحله قبلی عمیقتر شدهاست
- مردمک گشاد و پاسخ حداقل به نور
- اختلال عملکرد مختصر ولی پایدار کبد
مرحله V:
- این مرحله بدنبال مرحله چهار به سرعت بروز میکند
- کمای شدید و عمیق
- تشنج
- نارسایی چند ارگانی (Multiple organ failure)[10]
- شل شدن عضلات بدن (Flaccidity)
- بالا رفتن آمونیاک خون تا حد بیش از ۳۰۰ میلیگرم در دسیلیتر (Hyperammonemia)
- مرگ
منابع
- Pugliese, A; Beltramo, T; Torre, D (October 2008). "Reye's and Reye's-like syndromes". Cell biochemistry and function. 26 (7): 741–6. PMID 18711704.
- Pugliese, A; Beltramo, T; Torre, D (October 2008). "Reye's and Reye's-like syndromes.". Cell biochemistry and function. 26 (7): 741–6. PMID 18711704.
- Schrör, K (2007). "Aspirin and Reye syndrome: a review of the evidence.". Paediatric drugs. 9 (3): 195–204. PMID 17523700.
- "NINDS Reye's Syndrome Information Page". NINDS. September 25, 2009. Archived from the original on 1 August 2016. Retrieved 8 August 2016.
- Schrör, K (2007). "Aspirin and Reye syndrome: a review of the evidence". Paediatric drugs. 9 (3): 195–204. PMID 17523700.
- Knight, J. (2009). "Reye's Syndrome". Healthy Child Care. 12 (4).
- Boldt, D.W. (February 2003). "Reye Syndrome". University of Hawaii John A. Burns School of Medicine.
- "What is Reye's Syndrome?". National Reye's Syndrome Foundation.
- "Reye's Syndrome". KidsHealth.org. Nemour Foundation. Retrieved 2015-02-06.
- Ku AS, Chan LT (April 1999). "The first case of H5N1 avian influenza infection in a human with complications of adult respiratory distress syndrome and Reye's syndrome". Journal of Paediatrics and Child Health. 35 (2): 207–9. doi:10.1046/j.1440-1754.1999.t01-1-00329.x. PMID 10365363.
- مشارکتکنندگان ویکیپدیا. «Reye syndrome». در دانشنامهٔ ویکیپدیای انگلیسی، بازبینیشده در ۱۳ سپتامبر ۲۰۱۶.